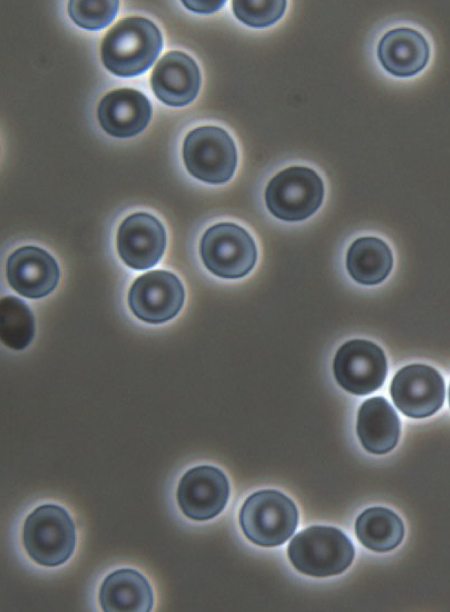

urine analysis is composed of two major parts
urine dip detects “blood” from three sources
if its in the pellet, it’s blood. if its in the supernatant, it’s just red pigment like Hb, Mb, or beet
Type of protein that can be detected by urine dip
albumin.
T/F a urine dipstick is good to see if someone has proteinuria
false. - generally turns positive at 300mg/day of albumin. ONLY POSITIVE AT SUPER HIGH LEVELS.
need to do an ACR and UTPCR
WBCs can be detected on urine dip, but can be suggestive of multitude of things such as inflammation or infection or interstitila nephritis (NSAIDS, alllopurinol, PPI, Infection or inflammation). What is more telling to further support infection?
NITRATES further support infection.
symptoms are most important differentiator. (dysuria, fever, flank pain)
for urine microscopy, if the supernatant is red vs if the pellet is red


The more dehydrated you are, the more hyaline casts
normal finding in everyone
Isomorphic Blood
This is strongly suggestive of lower urinary tract or post-
glomerular blood
58 M referred for persistent hematuria
No other symptoms
Ex-smoker – 40 pack year history
No meds
GFR 60 ml/min
Urine dips positive for blood and protein

dysmorphic RBC!
suggestive of aglomerular nephritis
TIA, PIG, ATN
T= thin basement membrane disease
I= IgA neph
A= allports
P= pauci-immune
I= immune complexes like Iga, lupus, strep
G= anti-GBM/goodpastures
M= MPGN
P= post infectious again with strep, legionella or CMV
L= LUPUS, sarocid, schrogrens
Should you give this person steroids

no This is not a dysmorphic red blood cell. This is segmenting yeast. If there’s yeast in their urine you shouldn’t give them steroids.
58 M
Complains of a 3 week history of a sore throat
Started on oral Keflex Doesn’t improve
Admitted to ICU with septic shock and found to have
bacteremia with a cephalosporin resistant Streptococcus
whats going on

ATN! Acute tubular necrosis AKI due to the kephlex. Toxin
classic triad of AIN
Rash, peripheral eosinophilia and white blood cell casts in urine –> classic triad of acute interstitial nephritis. Needs predinosine.

Needle shaped monohydrate calcium oxalate crystals seen only in Ethylene Glycol overdose
most common stones

Calcium oxalate stones are the most common stones.
COC can also be spherical
treatment of calcium oxalate stones
water
diet- sodium restriction, with calcium– do not restrict.

Looks like a coffin– struvite. Due to chronic infection in urinary tract. Hard to treat. Can get HUGE.
Stones
Calcium oxalate = envelopes, dumb bells or needles
Uric acid = rhomboid
Struvite = Coffin shaped
